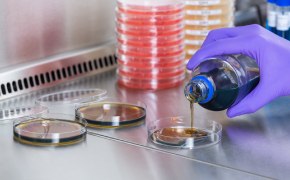
Large, brown solvent bottle with Supelco® branded label is opened by a lab worker wearing blue nitrile gloves. Only the hands and lower arms of the worker are shown. One small brown solvent bottle and two small white bottles can be seen in the background.

Characterization and quality control of monoclonal antibodies (mAbs) is essential to ensure their efficacy and safety. Analytical techniques, like HPLC and mass spectrometry, are vital to assess various properties, such as aggregation, charge variants, and post-translational modifications (PTMs). Our extensive selection of products supports the detailed analysis and evaluation of mAbs to maintain quality and effectiveness.
Microbiological Testing
Monoclonal antibodies are particularly notable for their targeted therapeutic benefits and minimal off-target adverse effects, distinguishing them in the market. Microbiological testing ensures product safety and regulatory compliance in the monoclonal antibody production process through methods like environmental air monitoring, sterility testing, pyrogen testing, and the use of culture media. Invest in appropriate contamination prevention products to improve the reliability of your analytical results and ensure speed-to-market.
As the significance of pharmaceuticals continues to rise, so does the demand for precise analytical testing. This testing includes bioburden, mycoplasma, pathogen, and spoilage assessments, as well as pyrogen and sterility evaluations, all vital for upholding the stringent safety and efficacy standards expected of pharmaceutical products. We invite you to explore our extensive array of industrial microbiology solutions that help maintain quality and consistency throughout your monoclonal antibody (mAb) production workflow.
Related Categories
Simplify your microbial limit testing workflow, from filtration to culturing and detection.
Tailor your Steritest® system to suit your sample, packaging, and controlled testing environment requirements.
Easy-to-use air samplers for active air monitoring in critical areas.
Pyrogen testing is vital to ensure the safety of pharmaceutical products and medical devices.
A wide range of dehydrated and ready-to-use culture media for your microbial testing needs.
Explore our diverse range of granulated and powdered biological raw materials in many varieties.
Related Resources
- Milliflex Oasis® Filtration System
Milliflex Oasis® system monitors bioburden in various samples, increasing lab productivity.
- Steritest® Symbio Sterility Testing Pump Guide
Steritest® Symbio system streamlines sterility testing, enhancing workflow, safety, and convenience in pharmaceutical quality control.
- Steritest® NEO Membrane Filtration Sterility Test
Sterility testing is one of the most crucial steps in pharmaceutical product release. Regulatory-compliant membrane filtration sterility testing devices ensure the safety of pharmaceutical products.
- Early Microbial Detection with Milliflex® Rapid System 2.0
Milliflex® Rapid System 2.0 accelerates microbial detection in quality control labs.
- Portable Microbial Air Samplers
Our active microbial air samplers generate accurate and reproducible results for effective use in pharmaceutical, medical device, food and beverage industries where regulations are on the rise, and standards become increasingly stringent.
- IsoBag® Rapid Transfer Solution Optimizes Your Environmental Monitoring Workflow
IsoBag® ease the environmental monitoring workflow in aseptic production isolator
- Environmental Sample Pre Storage on Counting Results
Microbial monitoring; environmental monitoring; interim storage; ICR contact plates; contact plates; TSA w. LTHThio Contact ICR+
- Application: Mycoplasma Testing in the Pharmaceutical Industry
Mycoplasmas testing is essential in pharmaceutical culture to detect contamination early and prevent production losses.
Related Webinars
Learn how proven ATP bioluminescence technology can reduce your time-to-result in microbial QC.
The long-awaited revised Annex 1 on the Manufacture of Sterile Medicinal Products was published by the European Commission on August 25th, 2022.
Compressed air and gases are used at different stages of many industrial manufacturing processes, so microbial compressed gas testing is an important part of contamination control programs.
In this lecture, you will learn how to test for pyrogen (including non-endotoxin pyrogens) in your pharmaceutical samples, what are the existing methods in order to have a controlled process.
The upcoming Annex 1 revision will include guidance specifically on designing a risk-based and effective contamination control strategy (CCS) based on a scientific assessment to understand the process and to apply risk management principles.
Environmental monitoring in a food manufacturing environment includes viable air sampling as well as surface sampling.
Explore our Products & Services
To continue reading please sign in or create an account.
Don't Have An Account?